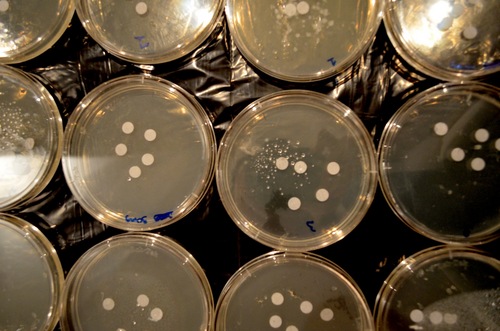

#scienceproject search results
Sınav Liseleri Bilimsel Proje Yarışması’nda öğrencilerimize katılım sertifikaları verildi.Öğrencilerimize yarışmaya gösterdikleri ilgi ve katkılarından dolayı teşekkür ederiz. Detaylar için tıklayınız: bit.ly/4tPo9es #sınaveğitimkurumları #scienceproject #sertifika




Have you used your library's makerspace or science databases? #scienceproject #scienceexperiment #libraries #makerspace ow.ly/5smo50TEm5w
Use a living plant as a capacitive touch sensor to make a bio-hybrid robot - student #STEM. #scienceproject #biohybrid #arduino #robotics youtube.com/shorts/YHa9bm5…

youtube.com
YouTube
Science Buddies
Terraforming project 🌏🌎🌍 academist-cf.com/projects/375?l… 🌱"Earth Regeneration & Terraforming Planets with Moss" 💚 【Earth】【Moon】【Mars】 Nice to know Wish you luck 🙏🏻🙏 #AcademyPartner #scienceProject #拡散希望 #disclosure #uapX #ufoX #環境 #uap #クラファン #Crowdfunding

Hi! I'm researching moss with enhanced environmental tolerance with Professor Fujita at Hokkaido University. To advance our work, we’ve launched a crowdfunding campaign! academist-cf.com/projects/375?l… Our goal is to develop plant-based solutions for space exploration, engineering moss
“कुछ नहीं करोगे तो कुछ नहीं होगा… पर try करोगे तो कुछ भी possible है 💯” Laser Traffic Light 🚦 Science Project by STEM ROBO HUB DM for custom projects StemRoboHub.com #STEM #ScienceProject #Robotics #Innovation #StartupIndia #TryKaro
I got my hip replaced exactly 6 weeks ago. I was cleared to run by my surgeon. Right back to normal? Not exactly 😂 But a good start 💪🏻 #totalhipreplacement #scienceproject #hooper #fuckcancer
DIY Mini Drone #STEM - add an accelerometer for motion control with the popsicle stick mini drone. Activity directions: sbgo.org/dronemotioncon… #drone #scienceproject

BLASTing Flu Viruses | It is no fun getting poked with a needle, but fortunately, a vaccine helps our immune system to develop protection against a serious illness for years to come. sciencebuddies.org/science-fair-p… via @ScienceBuddies #ScienceProject #SciEd #STEM #SciChat
How the Strength of a Magnet Varies with Temperature | Science Project - Here's an experiment on permanent magnets in "extreme kitchen" conditions that you can try at home. sciencebuddies.org/science-fair-p… via @ScienceBuddies #SciEd #STEM #ScienceProject #SciChat
Many of us use wireless devices, like cell phones, tablets, and laptops, every day. Measure How Wireless Signal Strength Changes with Distance Using a Micro:bit sciencebuddies.org/science-fair-p… via @ScienceBuddies #ScienceProject #STEM #SciEd #SciChat

What's the funniest or most creative school project your child has ever done? Let us know in the comments! #wvfue #schoolproject #scienceproject #socialstudiesproject #artproject #familyproject #schoolchoice
Do an experiment to find out! Watch the video to learn how to make a simple homemade fly trap using a plastic bottle. Which Bait Works Best for a Homemade Fly Trap? sciencebuddies.org/science-fair-p… via @ScienceBuddies #SciEd #STEM #ScienceProject #SciChat
There are many alternatives to plastic, and one popular product is beeswax wraps. Are beeswax wraps a suitable replacement for plastic wrap? | sciencebuddies.org/science-fair-p… via @ScienceBuddies #ScienceProject #SciEd #STEM #SciChat
Arduino Ultrasonic Levitator - It's not magic; it's science! Build your own acoustic levitator to make objects float in midair using invisible sound waves. sciencebuddies.org/science-fair-p… via @ScienceBuddies #STEM #ScienceProject #SciEd #SciChat
Have you ever seen a magician float an object in the air? You might think that levitation is just a magic trick, but the truth is you can use an invisible physical force to levitate a magnet! | sciencebuddies.org/science-fair-p… via @ScienceBuddies #ScienceProject #STEM #SciEd #SciChat
Can you guess which cell is which? 🤔 Ss got creative in science class today! We used Rice Krispy treats and candy to make edible models of plant and animal cells. #scienceproject #biology #stemlearning #RBBisBIA




Sound level meter and alarm with micro:bit: In this project, you will program a device that alerts you when sounds have exceeded safe levels long enough to cause hearing damage. sciencebuddies.org/science-fair-p… via @ScienceBuddies #STEM #ScienceProject #SciEd #SciChat
Biodiversity of Macroinvertebrates suceptible to pollution can be used as indicators of waterway health | Science Project sciencebuddies.org/science-fair-p… via @ScienceBuddies #ScienceProject #STEM #SciEd #SciChat
Satellite Collision Detection: A Hands-On Coding Experience - Use real satellite data to model orbits, track their movement, and predict potential collisions. | sciencebuddies.org/science-fair-p… via @ScienceBuddies #ScienceProject #STEM #SciEd #SciChat
Sınav Liseleri Bilimsel Proje Yarışması’nda öğrencilerimize katılım sertifikaları verildi.Öğrencilerimize yarışmaya gösterdikleri ilgi ve katkılarından dolayı teşekkür ederiz. Detaylar için tıklayınız: bit.ly/4tPo9es #sınaveğitimkurumları #scienceproject #sertifika




Mars Terrain Exploration: A Hands-On Coding Investigation - This project gives you hands-on insight into how computer science can help us investigate another world. sciencebuddies.org/science-fair-p… via @ScienceBuddies #ScienceProject #STEM #SciEd #SciChat
Use a living plant as a capacitive touch sensor to make a bio-hybrid robot - student #STEM. #scienceproject #biohybrid #arduino #robotics youtube.com/shorts/YHa9bm5…

youtube.com
YouTube
Science Buddies
“कुछ नहीं करोगे तो कुछ नहीं होगा… पर try करोगे तो कुछ भी possible है 💯” Laser Traffic Light 🚦 Science Project by STEM ROBO HUB DM for custom projects StemRoboHub.com #STEM #ScienceProject #Robotics #Innovation #StartupIndia #TryKaro
Solar System Model! ✨ . . . . . ہاشم کا زبردست سائنس پراجیکٹ! 🌍☀️ دیکھیے ہاشم کس طرح سورج، زمین اور چاند کی گردش کو واضح کر رہا ہے۔ #SolarSystem #ScienceProject #CreativeKids #Education #ApexTeam5 #family #motivation #viewers #trendingreels #shorts
fan controller experiment #shorts #scienceproject #experiment youtube.com/shorts/iLp_wGT… via @YouTube

youtube.com
YouTube
Tech Ideas
fan controller experiment #shorts #scienceproject #experiment youtube.com/shorts/iLp_wGT… via @YouTube

youtube.com
YouTube
Tech Ideas
From hydrogels to biofabrics made from seaweed, #STEM projects for students to explore environmental science and engineering for Earth Day. sbgo.org/plastics26-tw #scienceproject #EarthDay #EarthDay26

water purification working model for science project exhibition - diy - diypandit - creative - inspirea award project #wastewater #scienceproject #waterfilter #environment #cleanwater #filtration #studentproject #easyproject FULL VIDEO - youtu.be/2aPePbvc95E
#kindergarten #scienceproject #explodingcolors #magicmilk #schoolproject #schoollife shoutout to “My first Science Kit”
power supply experiment #shorts #scienceproject #experiment youtube.com/shorts/r2oogqy… via @YouTube

youtube.com
YouTube
Tech Ideas
Bioprinting: 3D Print with Living Cells! No 3D Printer Required: This process is similar to real 3D bio-printing techniques being explored to create tissues & organs. sciencebuddies.org/science-fair-p… via @ScienceBuddies #ScienceProject #STEM #SciEd #SciChat
automatic fire extinguisher science project - shorts - howtofunda FULL VIDEO - youtu.be/kg2zVqLYVIM #AutomaticFireExtinguisher #FireSafetyProject #ScienceProject #DIYScienceProject #SchoolScienceProject #InnovationProject #STEMProjects #ScienceExhibition #ViralProjects
April 1 is coming! Explore the science behind interesting optical illusions from the ambiguous cylinder to the wagon wheel effect. #STEM activities that "trick" the eye. sbgo.org/illusions26-tw #scienceteacher #scienceproject #STEM #aprilfools

tooth structure 3d model making for science project exhibition - diy - biology project | craftpiller #ToothStructure #ScienceProject #BiologyProject #ToothModel #BiologyDIY #CreativeLearning #STEMProject #handmademodel #craftpiller #biologyproject youtu.be/w4UbmzmABnM

youtube.com
YouTube
craftpiller
DIY Mini Drone #STEM - add an accelerometer for motion control with the popsicle stick mini drone. Activity directions: sbgo.org/dronemotioncon… #drone #scienceproject

Chitkarians of Grade 9 Alpha Traversed a Journey Through India's Space Missions to Commemorate National Space Day #CIS #newtonslawofmotion #scienceproject #learning #knowledge #ChitkaraInternationalSchool #projectbasedlearning




Can you guess which cell is which? 🤔 Ss got creative in science class today! We used Rice Krispy treats and candy to make edible models of plant and animal cells. #scienceproject #biology #stemlearning #RBBisBIA




Terraforming project 🌏🌎🌍 academist-cf.com/projects/375?l… 🌱"Earth Regeneration & Terraforming Planets with Moss" 💚 【Earth】【Moon】【Mars】 Nice to know Wish you luck 🙏🏻🙏 #AcademyPartner #scienceProject #拡散希望 #disclosure #uapX #ufoX #環境 #uap #クラファン #Crowdfunding

Hi! I'm researching moss with enhanced environmental tolerance with Professor Fujita at Hokkaido University. To advance our work, we’ve launched a crowdfunding campaign! academist-cf.com/projects/375?l… Our goal is to develop plant-based solutions for space exploration, engineering moss
Sınav Liseleri Bilimsel Proje Yarışması’nda öğrencilerimize katılım sertifikaları verildi.Öğrencilerimize yarışmaya gösterdikleri ilgi ve katkılarından dolayı teşekkür ederiz. Detaylar için tıklayınız: bit.ly/4tPo9es #sınaveğitimkurumları #scienceproject #sertifika




For their Collaborative Sciences Projects, our Grade 11 students explored various sciences to create team projects on topics like sports, coal mining, lifestyle choices, and more. #SISLearns #STEM #ScienceProject #CollaborativeScience




Congratulations to the winner and runners-up of this year’s Year 9 Science independent project where pupils are asked to research an area of science that interests them. Read more here: tinyurl.com/36crxr6z #science #scienceproject #education #year9

Many of us use wireless devices, like cell phones, tablets, and laptops, every day. Measure How Wireless Signal Strength Changes with Distance Using a Micro:bit sciencebuddies.org/science-fair-p… via @ScienceBuddies #ScienceProject #STEM #SciEd #SciChat

Young scientists techno utsav 2024 🔴 Get the latest headlines, updates, and live streams—follow SAL TV now! #technoutsav #scienceproject #StudentsCompetition #winners #education #newyear #saltvgoa #goanews #southgoa #salcete #saltvnews #breakingnews #konkani_news

Monkey Around Project - Worksheets are free to print (PDF files) for lower elementary Science students. #freeprintables #scienceproject #lowerelementary studenthandouts.com/science/lower-…

Seems that last minute school projects have many similarities, no matter the planet #aliens #UFO #ScienceProject

What happens when solar panels get covered with snow? Use a small solar panel and a multimeter to find out! sbgo.org/solarsnow26-tw #scienceproject #scienceteacher #electronics

Can you find microbes today that could have survived the different pH conditions of the early Earth's oceans? Explore with this astrobiology project. sbgo.org/modernmicrobes… #STEM #scienceproject #spacescience #microbiology #scichat

🌊 Exploring Erosion: In our BCI Science Class project, we're diving into the world of erosion. We're uncovering the forces that shape our landscapes. #ErosionScience #ScienceProject 🌍💧💨 @MiamiEastEL @MiamiOHSheriff @OhioAG




How do cats navigate the world? Students learn about somatosensation and use a maze to find out: sbgo.org/catwhiskers26-… #sciencefair #scienceproject #STEM #animalscience

How to tell WIND Direction! #WeatherVane #Shorts #ScienceProject youtube.com/shorts/h6-o0xl… via @YouTube

How does snow affect the voltage or power output of a solar panel? Put it to the test with a small solar panel and a multimeter. sbgo.org/solarsnow26-tw #scienceproject #sciencefair #winterSTEM #scichat

Something went wrong.
Something went wrong.
United States Trends
- 1. Spirit N/A
- 2. New Day N/A
- 3. Kofi N/A
- 4. Saka N/A
- 5. Big E N/A
- 6. Jeff Cobb N/A
- 7. Kentucky Derby N/A
- 8. Fulham N/A
- 9. Elizabeth Warren N/A
- 10. #ARSFUL N/A
- 11. #COYG N/A
- 12. Ask Jeeves N/A
- 13. Gyokeres N/A
- 14. Dagen N/A
- 15. Bradish N/A
- 16. Pocahontas N/A
- 17. #Its_SevEN_In_This_World N/A
- 18. Cody Bellinger N/A
- 19. Germany N/A
- 20. #Arsenal N/A